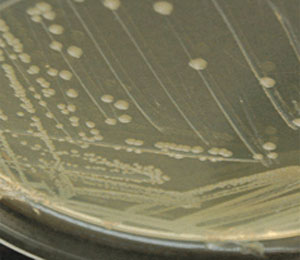
Esquerichia coli

Alternatives als antibiòtics: estudi comparatiu entre ribonucleases
Els microorganismes poden arribar a presentar resistència envers els antibiòtics quan s'ha produït un excés en el seu ús. Noves línies de recerca estan desenvolupant fàrmacs que minimitzin el risc...